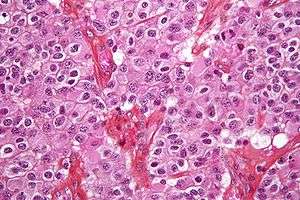

Brain tumor
| Brain tumor | |
|---|---|
|
Brain metastasis in the right cerebral hemisphere from lung cancer shown on magnetic resonance imaging. | |
| Classification and external resources | |
| Specialty | Neurosurgery, oncology |
| ICD-10 | D71, D33, |
| ICD-9-CM | 191, 225.0 |
| DiseasesDB | 30781 |
| MedlinePlus | 007222 000768 |
| eMedicine | emerg/334 |
| MeSH | D001932 |
A brain tumor or intracranial neoplasm occurs when abnormal cells form within the brain.[1] There are two main types of tumors: malignant or cancerous tumors and benign tumors.[1] Cancerous tumors can be divided into primary tumors that start within the brain, and secondary tumors that have spread from somewhere else, known as brain metastasis tumors.[2] All types of brain tumors may produce symptoms that vary depending on the part of the brain involved.[1] These symptoms may include headaches, seizures, problem with vision, vomiting, and mental changes.[2][3][1] The headache is classically worse in the morning and goes away with vomiting.[1] More specific problems may include difficulty in walking, speaking, and with sensation.[2][4] As the disease progresses unconsciousness may occur.[4]
The cause of most brain tumors is unknown.[1] Uncommon risk factors include inherited neurofibromatosis, exposure to vinyl chloride, Epstein–Barr virus, and ionizing radiation.[1][2][4] The evidence for mobile phones is not clear.[4] The most common types of primary tumors in adults are meningiomas (usually benign), and astrocytomas such as glioblastomas.[2] In children, the most common type is a malignant medulloblastoma.[4] Diagnosis is usually by medical examination along with computed tomography or magnetic resonance imaging.[1] This is then often confirmed by a biopsy.[2] Based on the findings, the tumors are divided into different grades of severity.[2]
Treatment may include some combination of surgery, radiation therapy and chemotherapy.[2] Anticonvulsant medication may be needed if seizures occur.[2] Dexamethasone and furosemide may be used to decrease swelling around the tumor.[2] Some tumors grow gradually, requiring only monitoring and possibly needing no further intervention.[2] Treatments that use a person's immune system are being studied.[1] Outcome varies considerably depending on the type of tumor and how far it has spread at diagnosis.[4] Glioblastomas usually have poor outcomes while meningiomas usually have good outcomes.[4] The average five-year survival rate for brain cancer in the United States is 33%.[5]
Secondary or metastatic brain tumors are more common than primary brain tumors,[1] with about half of metastases coming from lung cancer.[1] Primary brain tumors occur in around 250,000 people a year globally, making up less than 2% of cancers.[4] In children younger than 15, brain tumors are second only to acute lymphoblastic leukemia as a cause of cancer.[6] In Australia the average economic cost of a case of brain cancer is $1.9 million, the greatest of any type of cancer.[7]
Signs and symptoms

The signs and symptoms of brain tumors are broad. People with brain tumors will experience them no matter if the tumor is benign (not cancerous) or cancerous.[8] Primary and secondary brain tumors present with similar symptoms, with symptoms depend on the location, size, and rate of growth of the tumor.[9] For example, larger tumors in the frontal lobe can cause changes in the ability to think. However, a smaller tumor in an area such as Wernicke's area (small area responsible for language comprehension) can result in a greater loss of function.[10]
Intracranial pressure is usually the first sign of a brain tumor and it can cause persistent headaches.[11][12] These headaches may not respond to headache remedies and they may be accompanied by vomiting.[11]
The brain is divided into 4 lobes and each lobe or area has its own function.[13][14] A tumor in any of these lobes may affect the area's performance. The location of the tumor is often linked to the symptoms experienced but each person may experience something different.[15]
Frontal lobe tumors may contribute to poor reasoning, inappropriate social behavior, personality changes, poor planning, lower inhibition,[15] and decreased production of speech (Broca's area)
Temporal lobe: Tumors in this lobe may contribute to poor memory, loss of hearing,[14] difficulty in language comprehension (Wernicke's area)
Parietal lobe: Tumors here may result in poor interpretation of languages, decreased sense of touch and pain, and poor spatial and visual perception[16]
Occipital lobe: Damage to this lobe may result in poor or loss of vision[16]
Cerebellum: Tumors in this area may cause poor balance, muscle movement, and posture[16]
Brain stem: Tumors on this can affect blood pressure, swallowing, and heartbeat[14]
Behavior changes
Despite the personality and behavior changes occur in people with brain tumors, little research on such changes has been done.[13] A person's personality may be altered due to the tumor damaging lobes of the brain. Since the frontal, temporal, and parietal lobes[9] control inhibition, emotions, mood, judgement, reasoning, and behavior, a primary or secondary tumor in that region can cause inappropriate social behavior,[12] temper tantrums,[12] laughing at things which merit no laughter,[12] and even psychological symptoms such as depression and anxiety.[15]
Personality changes can have damaging effects such as unemployment, unstable relationships, and a lack of control.[13]
Cause
Epidemiological studies are required to determine risk factors.[17] Aside from exposure to vinyl chloride or ionizing radiation, there are no known environmental factors associated with brain tumors. Mutations and deletions of so-called tumor suppressor genes, such as P53, are thought to be the cause of some forms of brain tumor.[18] Inherited conditions, such as Von Hippel–Lindau disease, multiple endocrine neoplasia, and neurofibromatosis type 2 carry a high risk for the development of brain tumors.
Although studies have not shown any link between cell phone or mobile phone radiation and the occurrence of brain tumors,[19] the World Health Organization has classified mobile phone radiation on the IARC scale into Group 2B – possibly carcinogenic.[20] Discounting claims that current cell phone usage may cause brain cancer, modern, third-generation (3G) phones emit, on average, about 1% of the energy emitted by the GSM (2G) phones that were in use when epidemiological studies that observed a slight increase in the risk for glioma – a malignant type of brain cancer –among heavy users of wireless and cordless telephones were conducted.[4]
Pathophysiology

Meninges
Human brains are surrounded by a system of connective tissue membranes called meninges that separate the brain from the skull. This three-layered covering is composed of (from the outside in) the dura mater ("hard mother"), arachnoid mater ("spidery mother"), and pia mater ("tender mother"). The arachnoid and pia are physically connected and thus often considered as a single layer, the pia-arachnoid. Between the arachnoid mater and the pia mater is the subarachnoid space which contains cerebrospinal fluid (CSF). This fluid circulates in the narrow spaces between cells and through the cavities in the brain called ventricles, to nourish, support, and protect the brain tissue. Blood vessels enter the central nervous system through the perivascular space above the pia mater. The cells in the blood vessel walls are joined tightly, forming the blood–brain barrier which protects the brain from toxins that might enter through the blood. Tumors of the meninges are meningiomas and are often benign.
Brain matter
The brains of humans and other vertebrates are composed of very soft tissue and a gelatin-like texture. Living brain tissue has a pink tint in color on the outside (grey matter), and nearly complete white on the inside (white matter), with subtle variations in color. Three separate brain areas make up most of the brain's volume:
- telencephalon (cerebral hemispheres or cerebrum)
- mesencephalon (midbrain)
- cerebellum
These areas are composed of two broad classes of cells: neurons and glia. These two types are equally numerous in the brain as a whole, although glial cells outnumber neurons roughly 4 to 1 in the cerebral cortex. Glia come in several types, which perform a number of critical functions, including structural support, metabolic support, insulation, and guidance of development.
Primary tumors of the glial cells are called gliomas and often are malignant by the time they are diagnosed.
Spinal cord and other tissues
The pons in the brainstem is a specific region that consists of myelinated axons much like the spinal cord. The thalamus and hypothalamus of the diencephalon also consist of neuron and glial cell tissue with the hypophysis (pituitary gland) and pineal gland (which is glandular tissue) attached at the bottom; tumors of the pituitary and pineal gland are often benign. The medulla oblongata is at the start of the spinal cord and is composed mainly of neuron tissue enveloped in Schwann cells and meninges tissue. The spinal cord is made up of bundles of these axons. Glial cells such as Schwann cells in the periphery or, within the cord itself, oligodendrocytes, wrap themselves around the axon, thus promoting faster transmission of electrical signals and also providing for general maintenance of the environment surrounding the cord, in part by shuttling different compounds around in response to injury or other stimulus.
Diagnosis

Most of the brain is separated from the blood by the blood-brain barrier (BBB), which exerts a restrictive control as to which substances are allowed to pass. Therefore, many tracers that reach tumors in the body very easily would only reach brain tumors once there is a disruption of the BBB. Thus the disruption of the BBB, which can be detected by a MRI and CT, is regarded as the main diagnostic indicator for malignant gliomas, meningiomas, and brain metastases.[21]
Although there is no specific or singular clinical symptom or sign for any brain tumors, the presence of a combination of symptoms and the lack of corresponding clinical indications of infections or other causes can be an indicator to redirect diagnostic investigation towards the possibility of an intracranial neoplasm. Brain tumors have similar characteristics and obstacles when it comes to diagnosis and therapy with tumors located elsewhere in the body. However, they create specific issues that follow closely to the properties of the organ they are in.[21]
The diagnosis will often start by taking a medical history noting medical antecedents, and current symptoms. Clinical and laboratory investigations will serve to exclude infections as the cause of the symptoms. Examinations in this stage may include the eyes, otolaryngological (or ENT) and electrophysiological exams. The use of electroencephalography (EEG) often plays a role in the diagnosis of brain tumors.
Swelling, or obstruction of the passage of cerebrospinal fluid (CSF) from the brain may cause (early) signs of increased intracranial pressure which translates clinically into headaches, vomiting, or an altered state of consciousness, and in children changes to the diameter of the skull and bulging of the fontanelles. More complex symptoms such as endocrine dysfunctions should alarm doctors not to exclude brain tumors.
A bilateral temporal visual field defect (due to compression of the optic chiasm) or dilation of the pupil, and the occurrence of either slowly evolving or the sudden onset of focal neurologic symptoms, such as cognitive and behavioral impairment (including impaired judgment, memory loss, lack of recognition, spatial orientation disorders), personality or emotional changes, hemiparesis, hypoesthesia, aphasia, ataxia, visual field impairment, impaired sense of smell, impaired hearing, facial paralysis, double vision, or more severe symptoms such as tremors, paralysis on one side of the body hemiplegia, or (epileptic) seizures in a patient with a negative history for epilepsy, should raise the possibility of a brain tumor.
Imaging
Medical imaging plays a central role in the diagnosis of brain tumors. Early imaging methods—invasive and sometimes dangerous— such as pneumoencephalography and cerebral angiography have been abandoned in favor of non-invasive, high-resolution techniques, especially magnetic resonance imaging (MRI) and computed tomography (CT) scans. Neoplasms will often show as differently colored masses (also referred to as processes) in CT or MRI results.
- Benign brain tumors often show up as hypodense (darker than brain tissue) mass lesions on CT scans. On MRI, they appear either hypodense or isointense (same intensity as brain tissue) on T1-weighted scans, or hyperintense (brighter than brain tissue) on T2-weighted MRI, although the appearance is variable.
- Contrast agent uptake, sometimes in characteristic patterns, can be demonstrated on either CT or MRI scans in most malignant primary and metastatic brain tumors.
- Pressure areas where the brain tissue has been compressed by a tumor also appear hyperintense on T2-weighted scans and might indicate the presence a diffuse neoplasm due to an unclear outline. Swelling around the tumor known as peritumoral edema can also show a similar result.
This is because these tumors disrupt the normal functioning of the BBB and lead to an increase in its permeability. However, it is not possible to diagnose high- versus low-grade gliomas based on enhancement pattern alone.
The definitive diagnosis of brain tumor can only be confirmed by histological examination of tumor tissue samples obtained either by means of brain biopsy or open surgery. The histological examination is essential for determining the appropriate treatment and the correct prognosis. This examination, performed by a pathologist, typically has three stages: interoperative examination of fresh tissue, preliminary microscopic examination of prepared tissues, and follow-up examination of prepared tissues after immunohistochemical staining or genetic analysis.
Pathology
Tumors have characteristics that allow determination of malignacy and how they will evolve, and determining these characteristics will allow the medical team to determine the management plan.
Anaplasia or dedifferentiation: loss of differentiation of cells and of their orientation to one another and blood vessels, a characteristic of anaplastic tumor tissue. Anaplastic cells have lost total control of their normal functions and many have deteriorated cell structures. Anaplastic cells often have abnormally high nuclear-to-cytoplasmic ratios, and many are multinucleated. Additionally, the nuclei of anaplastic cells are usually unnaturally shaped or oversized. Cells can become anaplastic in two ways: neoplastic tumor cells can dedifferentiate to become anaplasias (the dedifferentiation causes the cells to lose all of their normal structure/function), or cancer stem cells can increase in their capacity to multiply (i.e., uncontrollable growth due to failure of differentiation).
Atypia: an indication of abnormality of a cell (which may be indicative for malignancy). Significance of the abnormality is highly dependent on context.
Neoplasia: the (uncontrolled) division of cells. As such, neoplasia is not problematic but its consequences are: the uncontrolled division of cells means that the mass of a neoplasm increases in size, and in a confined space such as the intracranial cavity this quickly becomes problematic because the mass invades the space of the brain pushing it aside, leading to compression of the brain tissue and increased intracranial pressure and destruction of brain parenchyma. Increased intracranial pressure (ICP) may be attributable to the direct mass effect of the tumor, increased blood volume, or increased cerebrospinal fluid (CSF) volume, which may in turn have secondary symptoms.
Necrosis: the (premature) death of cells, caused by external factors such as infection, toxin or trauma. Necrotic cells send the wrong chemical signals which prevents phagocytes from disposing of the dead cells, leading to a buildup of dead tissue, cell debris and toxins at or near the site of the necrotic cells[22]
Arterial and venous hypoxia, or the deprivation of adequate oxygen supply to certain areas of the brain, occurs when a tumor makes use of nearby blood vessels for its supply of blood and the neoplasm enters into competition for nutrients with the surrounding brain tissue.
More generally a neoplasm may cause release of metabolic end products (e.g., free radicals, altered electrolytes, neurotransmitters), and release and recruitment of cellular mediators (e.g., cytokines) that disrupt normal parenchymal function.
Classification
Secondary brain tumors
Secondary tumors of the brain are metastatic and have invaded the brain from cancers originating in other organs. This means that a cancerous neoplasm has developed in another organ elsewhere in the body and that cancer cells have leaked from that primary tumor and then entered the lymphatic system and blood vessels. They then circulate through the bloodstream, and are deposited in the brain. There, these cells continue growing and dividing, becoming another invasive neoplasm of the primary cancer's tissue. Secondary tumors of the brain are very common in the terminal phases of patients with an incurable metastasized cancer; the most common types of cancers that bring about secondary tumors of the brain are lung cancer, breast cancer, malignant melanoma, kidney cancer, and colon cancer (in decreasing order of frequency).
Secondary brain tumors are more common than primary ones; in the United States there are about 170,000 new cases every year. Secondary brain tumors are the most common cause of tumors in the intracranial cavity. The skull bone structure can also be subject to a neoplasm that by its very nature reduces the volume of the intracranial cavity, and can damage the brain.[23]
By behavior
Brain tumors or intracranial neoplasms can be cancerous (malignant) or non-cancerous (benign). However, the definitions of malignant or benign neoplasms differs from those commonly used in other types of cancerous or non-cancerous neoplasms in the body. In cancers elsewhere in the body, three malignant properties differentiate benign tumors from malignant forms of cancer: benign tumors are self-limited and do not invade or metastasize. Characteristics of malignant tumors include:
- uncontrolled mitosis (growth by division beyond the normal limits)
- anaplasia: the cells in the neoplasm have an obviously different form (in size and shape). Anaplastic cells display marked pleomorphism. The cell nuclei are characteristically extremely hyperchromatic (darkly stained) and enlarged; the nucleus might have the same size as the cytoplasm of the cell (nuclear-cytoplasmic ratio may approach 1:1, instead of the normal 1:4 or 1:6 ratio). Giant cells – considerably larger than their neighbors – may form and possess either one enormous nucleus or several nuclei (syncytia). Anaplastic nuclei are variable and bizarre in size and shape.
- invasion or infiltration (medical literature uses these terms as synonymous equivalents. However, for clarity, the articles that follow adhere to a convention that they mean slightly different things; this convention is not followed outside these articles):
- Invasion or invasiveness is the spatial expansion of the tumor through uncontrolled mitosis, in the sense that the neoplasm invades the space occupied by adjacent tissue, thereby pushing the other tissue aside and eventually compressing the tissue. Often these tumors are associated with clearly outlined tumors in imaging.
- Infiltration is the behavior of the tumor either to grow (microscopic) tentacles that push into the surrounding tissue (often making the outline of the tumor undefined or diffuse) or to have tumor cells "seeded" into the tissue beyond the circumference of the tumorous mass; this does not mean that an infiltrative tumor does not take up space or does not compress the surrounding tissue as it grows, but an infiltrating neoplasm makes it difficult to say where the tumor ends and the healthy tissue starts.
- metastasis (spread to other locations in the body via lymph or blood).
Of the above malignant characteristics, some elements do not apply to primary neoplasms of the brain:
- Primary brain tumors rarely metastasize to other organs; some forms of primary brain tumors can metastasize but will not spread outside the intracranial cavity or the central spinal canal. Due to the BBB, cancerous cells of a primary neoplasm cannot enter the bloodstream and get carried to another location in the body. (Occasional isolated case reports suggest spread of certain brain tumors outside the central nervous system, e.g. bone metastasis of glioblastoma multiforme.[24])
- Primary brain tumors generally are invasive (i.e. they will expand spatially and intrude into the space occupied by other brain tissue and compress those brain tissues); however, some of the more malignant primary brain tumors will infiltrate the surrounding tissue.
Of numerous grading systems in use for the classification of tumor of the central nervous system, the World Health Organization (WHO) grading system is commonly used for astrocytoma. Established in 1993 in an effort to eliminate confusion regarding diagnoses, the WHO system established a four-tiered histologic grading guideline for astrocytomas that assigns a grade from 1 to 4, with 1 being the least aggressive and 4 being the most aggressive.
Types
Tumors can be benign or malignant, can occur in different parts of the brain, and may be primary or secondary. A primary tumor is one that has started in the brain, as opposed to a metastatic tumor, which is something that has spread to the brain from another part of the body.[25] The incidence of metastatic tumors are more prevalent than primary tumors by 4:1.[26] Tumors may or may not be symptomatic: some tumors are discovered because the patient has symptoms, others show up incidentally on an imaging scan, or at an autopsy.
The most common primary brain tumors are:[27]
- Gliomas (50.4%)
- Meningiomas (20.8%)
- Pituitary adenomas (15%)
- Nerve sheath tumors (8%)
These common tumors can also be organized according to tissue of origin as shown below:[28]
|
Tissue of origin |
Children | Adults |
|---|---|---|
| Astrocytes | Pilocytic Astrocytoma (PCA) | Glioblastoma Multiforme (GBM) |
| Oligodendrocytes | Oligodendroglioma | |
| Ependyma | Ependymoma | |
| Neurons | Medulloblastoma | |
| Meninges | Meningioma |
Specific types
Anaplastic astrocytoma, Astrocytoma, Central neurocytoma, Choroid plexus carcinoma, Choroid plexus papilloma, Choroid plexus tumor, Dysembryoplastic neuroepithelial tumour, Ependymal tumor, Fibrillary astrocytoma, Giant-cell glioblastoma, Glioblastoma multiforme, Gliomatosis cerebri, Gliosarcoma, Hemangiopericytoma, Medulloblastoma, Medulloepithelioma, Meningeal carcinomatosis, Neuroblastoma, Neurocytoma, Oligoastrocytoma, Oligodendroglioma, Optic nerve sheath meningioma, Pediatric ependymoma, Pilocytic astrocytoma, Pinealoblastoma, Pineocytoma, Pleomorphic anaplastic neuroblastoma, Pleomorphic xanthoastrocytoma, Primary central nervous system lymphoma, Sphenoid wing meningioma, Subependymal giant cell astrocytoma, Subependymoma, Trilateral retinoblastoma.
Treatment
When a brain tumor is diagnosed, a medical team will be formed to assess the treatment options presented by the leading surgeon to the patient and his/her family. Given the location of primary solid neoplasms of the brain in most cases a "do-nothing" option is usually not presented. Neurosurgeons take the time to observe the evolution of the neoplasm before proposing a management plan to the patient and his/her relatives. These various types of treatment are available depending on neoplasm type and location and may be combined to give the best chances of survival:
- Surgery: complete or partial resection of the tumor with the objective of removing as many tumor cells as possible.
- Radiotherapy: the most commonly used treatment for brain tumors; the tumor is irradiated with beta, x rays or gamma rays.
- Chemotherapy: is a treatment option for cancer, however it is not always used to treat brain tumors as the blood-brain barrier can prevent some drugs from reaching the cancerous cells.
- A variety of experimental therapies are available through clinical trials.
Survival rates in primary brain tumors depend on the type of tumor, age, functional status of the patient, the extent of surgical tumor removal and other factors specific to each case.[29]
Surgery
The primary and most desired course of action described in medical literature is surgical removal (resection) via craniotomy. Minimally invasive techniques are becoming the dominant trend in neurosurgical oncology.[30] The prime remediating objective of surgery is to remove as many tumor cells as possible, with complete removal being the best outcome and cytoreduction ("debulking") of the tumor otherwise. In some cases access to the tumor is impossible and impedes or prohibits surgery.
Many meningiomas, with the exception of some tumors located at the skull base, can be successfully removed surgically. Most pituitary adenomas can be removed surgically, often using a minimally invasive approach through the nasal cavity and skull base (trans-nasal, trans-sphenoidal approach). Large pituitary adenomas require a craniotomy (opening of the skull) for their removal. Radiotherapy, including stereotactic approaches, is reserved for inoperable cases.
Several current research studies aim to improve the surgical removal of brain tumors by labeling tumor cells with 5-aminolevulinic acid that causes them to fluoresce.[31] Postoperative radiotherapy and chemotherapy are integral parts of the therapeutic standard for malignant tumors. Radiotherapy may also be administered in cases of "low-grade" gliomas, when a significant tumor burden reduction could not be achieved surgically.
Any person undergoing brain surgery may suffer from epileptic seizures. These can take the form of either absence seizures or tonic-clonic seizures. Medication can lessen and sometimes prevent these attacks.
Multiple metastatic tumors are generally treated with radiotherapy and chemotherapy rather than surgery and the prognosis in such cases is determined by the primary tumor, and is generally poor.
Radiation therapy
The goal of radiation therapy is to kill tumor cells while leaving normal brain tissue unharmed. In standard external beam radiation therapy, multiple treatments of standard-dose "fractions" of radiation are applied to the brain. This process is repeated for a total of 10 to 30 treatments, depending on the type of tumor. This additional treatment provides some patients with improved outcomes and longer survival rates.
Radiosurgery is a treatment method that uses computerized calculations to focus radiation at the site of the tumor while minimizing the radiation dose to the surrounding brain. Radiosurgery may be an adjunct to other treatments, or it may represent the primary treatment technique for some tumors. Forms used include stereotactic radiosurgery, such as Gamma knife, Cyberknife or Novalis Tx radiosurgery.[32]
Radiotherapy may be used following, or in some cases in place of, resection of the tumor. Forms of radiotherapy used for brain cancer include external beam radiation therapy, the most common, and brachytherapy and proton therapy, the last especially used for children.
Radiotherapy is the most common treatment for secondary brain tumors. The amount of radiotherapy depends on the size of the area of the brain affected by cancer. Conventional external beam "whole-brain radiotherapy treatment" (WBRT) or "whole-brain irradiation" may be suggested if there is a risk that other secondary tumors will develop in the future.[33] Stereotactic radiotherapy is usually recommended in cases involving fewer than three small secondary brain tumors.
People who receive stereotactic radiosurgery (SRS) and whole-brain radiation therapy (WBRT) for the treatment of metastatic brain tumors have more than twice the risk of developing learning and memory problems than those treated with SRS alone.[34][35]
Chemotherapy
Patients undergoing chemotherapy are administered drugs designed to kill tumor cells. Although chemotherapy may improve overall survival in patients with the most malignant primary brain tumors, it does so in only about 20 percent of patients. Chemotherapy is often used in young children instead of radiation, as radiation may have negative effects on the developing brain. The decision to prescribe this treatment is based on a patient's overall health, type of tumor, and extent of the cancer. The toxicity and many side effects of the drugs, and the uncertain outcome of chemotherapy in brain tumors puts this treatment further down the line of treatment options with surgery and radiation therapy preferred.
UCLA Neuro-Oncology publishes real-time survival data for patients with a diagnosis of glioblastoma multiforme. They are the only institution in the United States that displays how brain tumor patients are performing on current therapies. They also show a listing of chemotherapy agents used to treat high-grade glioma tumors.[36]
Other
A shunt may be used to relieve symptoms caused by intracranial pressure, by reducing the build-up of fluid (hydrocephalus) caused by the blockage of the free flow of cerebrospinal fluid.[37]
Prognosis
The prognosis of brain cancer depends on the type of cancer diagnosed. Medulloblastoma has a good prognosis with chemotherapy, radiotherapy, and surgical resection while glioblastoma multiforme has a median survival of only 12 months even with aggressive chemoradiotherapy and surgery. Brainstem gliomas have the poorest prognosis of any form of brain cancer, with most patients dying within one year, even with therapy that typically consists of radiation to the tumor along with corticosteroids. However, one type, focal brainstem gliomas in children, seems open to exceptional prognosis and long-term survival has frequently been reported.[38]
Glioblastoma multiforme
Glioblastoma multiforme is the most aggressive (grade IV) and most common form of a malignant brain tumor. Even when aggressive multimodality therapy consisting of radiotherapy, chemotherapy, and surgical excision is used, median survival is only 12–17 months. Standard therapy for glioblastoma multiforme consists of maximal surgical resection of the tumor, followed by radiotherapy between two and four weeks after the surgical procedure to remove the cancer, then by chemotherapy. Most patients with glioblastoma take a corticosteroid, typically dexamethasone, during their illness to relieve symptoms. Experimental treatments include gamma knife radiosurgery,[39] boron neutron capture therapy and gene therapy.[40][41]
Oligodendrogliomas
Oligodendrogliomas are incurable but slowly progressive malignant brain tumors. They can be treated with surgical resection, chemotherapy, radiotherapy or a combination. For some suspected low-grade (grade II) tumors, only a course of watchful waiting and symptomatic therapy is opted for. These tumors show a high frequency of co-deletions of the p and q arms of chromosome 1 and chromosome 19 respectively (1p19q co-deletion) and have been found to be especially chemosensitive with one report claiming them to be one of the most chemosensitive tumors.[42] A median survival of up to 16.7 years has been reported for grade II oligodendrogliomas.[43]
Epidemiology
Figures for incidences of cancers of the brain show a significant difference between more- and less-developed countries (the less-developed countries have lower incidences of tumors of the brain),[44]— this could be explained by undiagnosed tumor-related deaths (patients in extreme poor situations do not get diagnosed, simply because they do not have access to the modern diagnostic facilities required to diagnose a brain tumor) and by deaths caused by other poverty-related causes that preempt a patient's life before tumors develop or tumors become life-threatening. Nevertheless, studies suggest that certain forms of primary brain tumors are more prevalent among certain groups of the population.
The incidence of low-grade astrocytoma has not been shown to vary significantly with nationality. However, studies examining the incidence of malignant central nervous system (CNS) tumors have shown some variation with national origin. Since some high-grade lesions arise from low-grade tumors, these trends are worth mentioning. Specifically, the incidence of CNS tumors in the United States, Israel, and the Nordic countries is relatively high, while Japan and Asian countries have a lower incidence. These differences probably reflect some biological differences as well as differences in pathologic diagnosis and reporting.[45] Worldwide data on incidence of cancer can be found at the WHO (World Health Organisation) and is handled by the IARC (International Agency for Research on Cancer) located in France.[46]
United States
For the United States in the year 2005, it was projected that there would be 43,800 new cases of brain tumors[47][48] which accounted for less than 1 percent of all cancers, 2.4 percent of all cancer deaths,[49] and 20–25 percent of pediatric cancers.[49][50] Ultimately, it is estimated there are 13,000 deaths per year in the United States alone as a result of brain tumors.[48]
UK
Brain, other CNS or intracranial tumors are the ninth most common cancer in the UK (around 10,600 people were diagnosed in 2013), and it is the eighth most common cause of cancer death (around 5,200 people died in 2012).[51]
Research
Immunotherapy
Cancer immunotherapy is being actively studied. For malignant gliomas no therapy has been shown to improve life expectancy as of 2015.[52]
Vesicular stomatitis virus
In 2000, researchers used the vesicular stomatitis virus, or VSV, to infect and kill cancer cells without affecting healthy cells.[53][54]
The initial discovery of the virus' oncolytic properties were limited to only a few types of cancer. Several independent studies have identified many more types susceptible to the virus, including glioblastoma multiforme cancer cells, which account for the majority of brain tumors.
In 2008, researchers artificially engineered strains of VSV that were less cytotoxic to normal cells. This advance allows administration of the virus without coadministration with interferon. Consequently, administration of the virus can be given intravenously or through the olfactory nerve. In the research, a human brain tumor was implanted into mice brains.
Research on virus treatment like this has been conducted for some years, but no other viruses have been shown to be as efficient or specific as the VSV mutant strains.
Retroviral replicating vectors
Led by Prof. Nori Kasahara, researchers from USC, who are now at UCLA, reported in 2001 the first successful example of applying the use of retroviral replicating vectors towards transducing cell lines derived from solid tumors.[55] Building on this initial work, the researchers applied the technology to in vivo models of cancer and in 2005 reported a long-term survival benefit in an experimental brain tumor animal model.[56] Subsequently, in preparation for human clinical trials, this technology was further developed by Tocagen (a pharmaceutical company primarily focused on brain cancer treatments) as a combination treatment (Toca 511 & Toca FC). This has been under investigation since 2010 in a Phase I/II clinical trial for the potential treatment of recurrent high-grade glioma including glioblastoma multiforme (GBM) and anaplastic astrocytoma. No results have yet been published.[57]
Children
In the USA, about 2,000 children and adolescents younger than 20 years of age are diagnosed with malignant brain tumors each year. Higher incidence rates were reported in 1985–1994 than in 1975–1983. There is some debate as to the reasons; one theory is that the trend is the result of improved diagnosis and reporting, since the jump occurred at the same time that MRIs became available widely, and there was no coincident jump in mortality. The central nervous system cancer survival rate in children is approximately 60%. The rate varies with the type of cancer and the age of onset: younger patients have higher mortality.[58]
In children under 2, about 70% of brain tumors are medulloblastomas, ependymomas, and low-grade gliomas. Less commonly, and seen usually in infants, are teratomas and atypical teratoid rhabdoid tumors.[59] Germ cell tumors, including teratomas, make up just 3% of pediatric primary brain tumors, but the worldwide incidence varies significantly.[60]
In the UK, 429 children aged 14 and under are diagnosed with a brain tumour on average each year, and 563 children and young people under the age of 19 are diagnosed.[61]
See also
References
- 1 2 3 4 5 6 7 8 9 10 11 "General Information About Adult Brain Tumors". NCI. 2014-04-14. Retrieved 8 June 2014.
- 1 2 3 4 5 6 7 8 9 10 11 "Adult Brain Tumors Treatment". NCI. 2014-02-28. Retrieved 8 June 2014.
- ↑ Longo, Dan L (2012). "369 Seizures and Epilepsy". Harrison's principles of internal medicine (18th ed.). McGraw-Hill. p. 3258. ISBN 978-0-07-174887-2.
- 1 2 3 4 5 6 7 8 9 World Cancer Report 2014. World Health Organization. 2014. pp. Chapter 5.16. ISBN 9283204298.
- ↑ "SEER Stat Fact Sheets: Brain and Other Nervous System Cance". NCI. Retrieved 18 June 2014.
- ↑ World Cancer Report 2014. World Health Organization. 2014. pp. Chapter 1.3. ISBN 9283204298.
- ↑ "Brain Tumour Facts 2011". Brain Tumour Alliance Australia. Archived from the original (PDF) on 20 Nov 2014. Retrieved 9 June 2014.
- ↑ "Brain Tumors". Retrieved 2016-08-02.
- 1 2 "Mood Swings and Cognitive Changes | American Brain Tumor Association". www.abta.org. Retrieved 2016-08-03.
- ↑ "Coping With Personality & Behavioral Changes". www.brainsciencefoundation.org. Retrieved 2016-08-03.
- 1 2 "Headaches | American Brain Tumor Association". www.abta.org. Retrieved 2016-08-03.
- 1 2 3 4 Jones, Caleb. "Brain Tumor Symptoms | Miles for Hope | Brain Tumor Foundation". milesforhope.org. Retrieved 2016-08-03.
- 1 2 3 Gregg, N. (2014). ""Neurobehavioural Changes In Patients Following Brain Tumour: Patients And Relatives Perspective."". Supportive Care In Cancer.
- 1 2 3 "Coping With Personality & Behavioral Changes". www.brainsciencefoundation.org. Retrieved 2016-07-27.
- 1 2 3 "Mood Swings and Cognitive Changes | American Brain Tumor Association". www.abta.org. Retrieved 2016-07-27.
- 1 2 3 "Anatomy of the Brain" (PDF).
- ↑ Krishnatreya, M; Kataki, AC; Sharma, JD; Bhattacharyya, M; Nandy, P; Hazarika, M (2014). "Brief descriptive epidemiology of primary malignant brain tumors from North-East India.". Asian Pacific Journal of Cancer Prevention. 15 (22): 9871–3. doi:10.7314/apjcp.2014.15.22.9871. PMID 25520120.
- ↑ Kleihues P, Ohgaki H, Eibl RH, Reichel MB, Mariani L, Gehring M, Petersen I, Höll T, von Deimling A, Wiestler OD, Schwab M (1994). "Type and frequency of p53 mutations in tumors of the nervous system and its coverings". Molecular Neuro-oncology and Its Impact on the Clinical Management of Brain Tumors. Recent results in cancer research. 135. Springer. pp. 25–31. ISBN 3540573518.
- ↑ Frei P, Poulsen AH, Johansen C, Olsen JH, Steding-Jessen M, Schüz J (19 October 2011). "Use of mobile phones and risk of brain tumours: update of Danish cohort study.". BMJ. 343: d6387. doi:10.1136/bmj.d6387. PMC 3197791
. PMID 22016439. - ↑ "IARC classifies radiofrequency electromagnetic fields as possibly carcinogenic to humans" (PDF). World Health Organization press release N° 208 (Press release). International Agency for Research on Cancer. 31 May 2011. Retrieved 2 June 2011.
- 1 2 Herholz, Karl; Langen, Karl-Josef; Schiepers, Christiaan; Mountz, James M. (2012). "Brain Tumors". Seminars in Nuclear Medicine. 42 (6): 356–70. doi:10.1053/j.semnuclmed.2012.06.001. PMC 3925448
. PMID 23026359. - ↑ MedlinePlus Encyclopedia Necrosis
- ↑ MedlinePlus Encyclopedia Metastatic brain tumor
- ↑ Frappaz D, Mornex F, Saint-Pierre G, Ranchere-Vince D, Jouvet A, Chassagne-Clement C, Thiesse P, Mere P, Deruty R (1999). "Bone metastasis of glioblastoma multiforme confirmed by fine needle biopsy". Acta Neurochirurgica. 141 (5): 551–552. doi:10.1007/s007010050342. PMID 10392217.
- ↑ "What you need to know about brain tumors". National Cancer Institute. Retrieved 25 February 2012.
- ↑ Merrel RT (Dec 2012). "Brain tumors.". Dis Mon. 58 (12): 678–89. doi:10.1016/j.disamonth.2012.08.009. PMID 23149521.
- ↑ Park, Bong Jin; Kim, Han Kyu; Sade, Burak; Lee, Joung H. (2009). "Epidemiology". In Lee, Joung H. Meningiomas: Diagnosis, Treatment, and Outcome. Springer. p. 11. ISBN 978-1-84882-910-7.
- ↑ Sattar, Husain A. Pathoma.com
- ↑ Nicolato, Antonio; Gerosa, Massimo A.; Fina, Paolo; Iuzzolino, Paolo; Giorgiutti, Fabrizia; Bricolo, Albino (1995). "Prognostic factors in low-grade supratentorial astrocytomas: A uni-multivariate statistical analysis in 76 surgically treated adult patients". Surgical Neurology. 44 (3): 208–21; discussion 221–3. doi:10.1016/0090-3019(95)00184-0. PMID 8545771.
- ↑ Spetzler RF, Sanai N (2012). "The quiet revolution: Retractorless surgery for complex vascular and skull base lesions". Journal of Neurosurgery. 116 (2): 291–300. doi:10.3171/2011.8.JNS101896. PMID 21981642.
- ↑ Paul Brennan (4 August 2008). "Introduction to brain cancer". cliniclog.com. Retrieved 19 December 2011.
- ↑ "Radiosurgery treatment comparisons – Cyberknife, Gamma knife, Novalis Tx". Retrieved 22 July 2014.
- ↑ "Treating secondary brain tumours with WBRT". Cancer Research UK. Retrieved 5 June 2012.
- ↑ "Whole Brain Radiation increases risk of learning and memory problems in cancer patients with brain metastases". MD Anderson Cancer Center. Retrieved 5 June 2012.
- ↑ "Metastatic brain tumors". International RadioSurgery Association. Retrieved 5 June 2012.
- ↑ "How Our Patients Perform: Glioblastoma Multiforme". UCLA Neuro-Oncology Program. Retrieved 5 June 2012.
- ↑ Dalvi A. "Normal Pressure Hydrocephalus Causes, Symptoms, Treatment". eMedicineHealth. Emedicinehealth.com. Retrieved 17 February 2012.
- ↑ "Brain Stem Gliomas in Childhood". Childhoodbraintumor.org. Retrieved 17 February 2012.
- ↑ "GBM Guide – MGH Brain Tumor Center". Brain.mgh.harvard.edu. Retrieved 17 February 2012.
- ↑ Chien-Kuo Tai; Noriyuki Kasahara (1 January 2008). "Replication-competent retrovirus vectors for cancer gene therapy" (PDF). Frontiers in Bioscience. 13: 3083–3095. doi:10.2741/2910. PMID 17981778.
- ↑ Murphy AM, Rabkin SD (Apr 2013). "Current status of gene therapy for brain tumors". Transl. Res. 161 (4): 339–54. doi:10.1016/j.trsl.2012.11.003. PMID 23246627.
- ↑ Ty AU, See SJ, Rao JP, Khoo JB, Wong MC (January 2006). "Oligodendroglial tumor chemotherapy using "decreased-dose-intensity" PCV: a Singapore experience". Neurology. 66 (2): 247–9. doi:10.1212/01.wnl.0000194211.68164.a0. PMID 16434664.
- ↑ "Neurology". Neurology. Retrieved 17 February 2012.
- ↑ Bondy ML, Scheurer ME, Malmer B, et al. (2008). "Brain Tumor Epidemiology: Consensus from the Brain Tumor Epidemiology Consortium (BTEC)". Cancer. 113 (7 Suppl): 1953–1968. doi:10.1002/cncr.23741.
- ↑ Jallo GI, Benardete EA (January 2010). "Low-Grade Astrocytoma".
- ↑ "CANCERMondial". International Agency for Research on Cancer. Retrieved 17 February 2012.
- ↑ "Central Brain Tumor Registry of the United States, Primary Brain Tumors in the United States, Statistical Report, 2005–2006" (PDF). Retrieved 23 July 2014.
- 1 2 Greenlee RT, Murray T, Bolden S, Wingo PA (2000). "Cancer statistics, 2000". CA Cancer J Clin. 50 (1): 7–33. doi:10.3322/canjclin.50.1.7. PMID 10735013.
- 1 2 "What are the key statistics about brain and spinal cord tumors?". American Cancer Society. May 1, 2012.
- ↑ Chamberlain MC, Kormanik PA (February 1998). "Practical guidelines for the treatment of malignant gliomas". West. J. Med. 168 (2): 114–20. PMC 1304839
. PMID 9499745.
- ↑ "Brain, other CNS and intracranial tumours statistics". Cancer Research UK. Retrieved 27 October 2014.
- ↑ Bloch, O (2015). "Immunotherapy for malignant gliomas.". Cancer Treatment and Research. 163: 143–58. doi:10.1007/978-3-319-12048-5_9. PMID 25468230.
- ↑ Auer R, Bell JC (January 2012). "Oncolytic viruses: smart therapeutics for smart cancers". Future Oncology. 8 (1): 1–4. doi:10.2217/fon.11.134. PMID 22149027.
- ↑ Garber K (1 March 2006). "China Approves World's First Oncolytic Virus Therapy For Cancer Treatment". J Natl Cancer Inst. 98 (5): 298–300. doi:10.1093/jnci/djj111. PMID 16507823.
- ↑ Logg CR, Tai CK, Logg A, Anderson WF, Kasahara N (20 May 2001). "A uniquely stable replication-competent retrovirus vector achieves efficient gene delivery in vitro and in solid tumors". Human Gene Therapy. 12 (8): 921–932. doi:10.1089/104303401750195881. PMID 11387057.
- ↑ Tai CK, Wang WJ, Chen TC, Kasahara N (November 2005). "Single-shot, multicycle suicide gene therapy by replication-competent retrovirus vectors achieves long-term survival benefit in experimental glioma". Molecular Therapy. 12 (5): 842–851. doi:10.1016/j.ymthe.2005.03.017. PMID 16257382.
- ↑ "A Study of a Retroviral Replicating Vector Administered to Subjects With Recurrent Malignant Glioma". Clinical Trials.gov. July 2014.
- ↑ Gurney JG, Smith MA, Bunin GR. "CNS and Miscellaneous Intracranial and Instraspinal Neoplasms" (PDF). SEER Pediatric Monograph. National Cancer Institute. pp. 51–57. Retrieved 4 December 2008.
In the US, approximately 2,200 children and adolescents younger than 20 years of age are diagnosed with malignant central nervous system tumors each year. More than 90 percent of primary CNS malignancies in children are located within the brain.
- ↑ Rood BR. "Infantile Brain Tumors". The Childhood Brain Tumor Foundation. Retrieved 23 July 2014.
- ↑ Echevarría ME, Fangusaro J, Goldman S (June 2008). "Pediatric central nervous system germ cell tumors: a review". Oncologist. 13 (6): 690–9. doi:10.1634/theoncologist.2008-0037. PMID 18586924.
- ↑ "About childhood brain tumours". Retrieved 16 June 2016.
External links
| Wikimedia Commons has media related to Brain neoplasms. |
- Brain and CNS cancers at DMOZ
- Brain tumour information from Cancer Research UK
- Neuro-Oncology: Cancer Management Guidelines
- MedPix Teaching File MR Scans of Primary Brain Lymphoma, etc.
